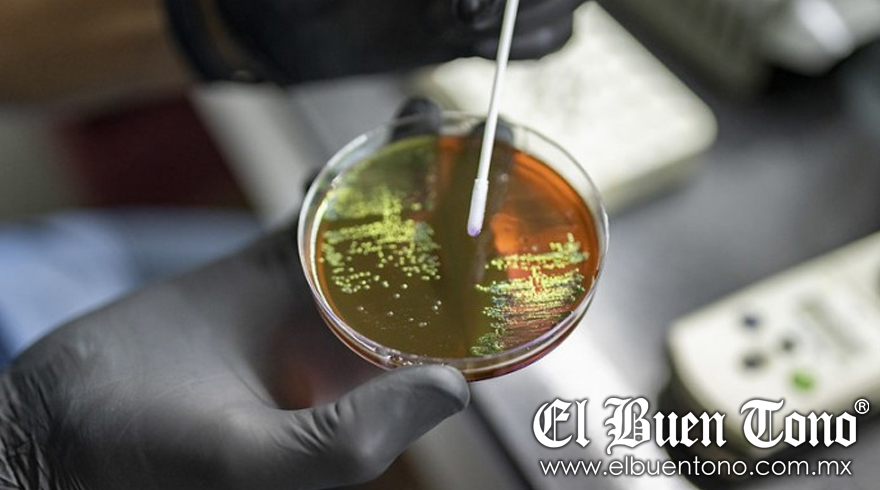

AGENCIA
Xalapa, Ver.- El estado de Veracruz ha registrado 78 casos de hepatitis tipo A en lo que va del año, casi el doble en comparación con el mismo periodo de 2023. Según datos de la Secretaría de Salud federal, del total de casos en 2024, 42 corresponden a hombres y 36 a mujeres. Este aumento coloca a Veracruz en el séptimo lugar a nivel nacional entre los estados con más casos reportados hasta febrero pasado.
El estado con el mayor número de casos confirmados es Coahuila, con 421 casos, seguido por Ciudad de México con 248 y Guanajuato con 155. Otros estados con números elevados son el Estado de México con 119 casos, Chiapas con 102 y Jalisco con 95. En total, a nivel nacional, se han reportado mil 938 casos de hepatitis tipo A, un incremento significativo en comparación con el mismo periodo de 2023, cuando se contabilizaron mil 589.
La hepatitis tipo A es una infección aguda que se propaga principalmente a través del agua o alimentos contaminados, o por el contacto con una persona infectada. Los síntomas más comunes incluyen fatiga, náuseas, dolor abdominal, pérdida del apetito y febrícula. Afortunadamente, la enfermedad suele desaparecer sin necesidad de tratamiento después de uno o dos meses. El reposo y la hidratación adecuada son clave para la recuperación.
Las autoridades sanitarias recomiendan extremar precauciones y tomar medidas para prevenir el contagio. Entre estas, se sugiere consumir agua potable segura, lavar adecuadamente los alimentos y las manos con frecuencia, especialmente después de usar el baño y antes de comer o preparar alimentos.
El aumento en los casos de hepatitis tipo A en Veracruz y en el país subraya la importancia de mantener altos estándares de higiene y seguridad alimentaria para reducir el riesgo de infecciones. Las autoridades continuarán monitoreando la situación y emitiendo recomendaciones para proteger la salud pública.